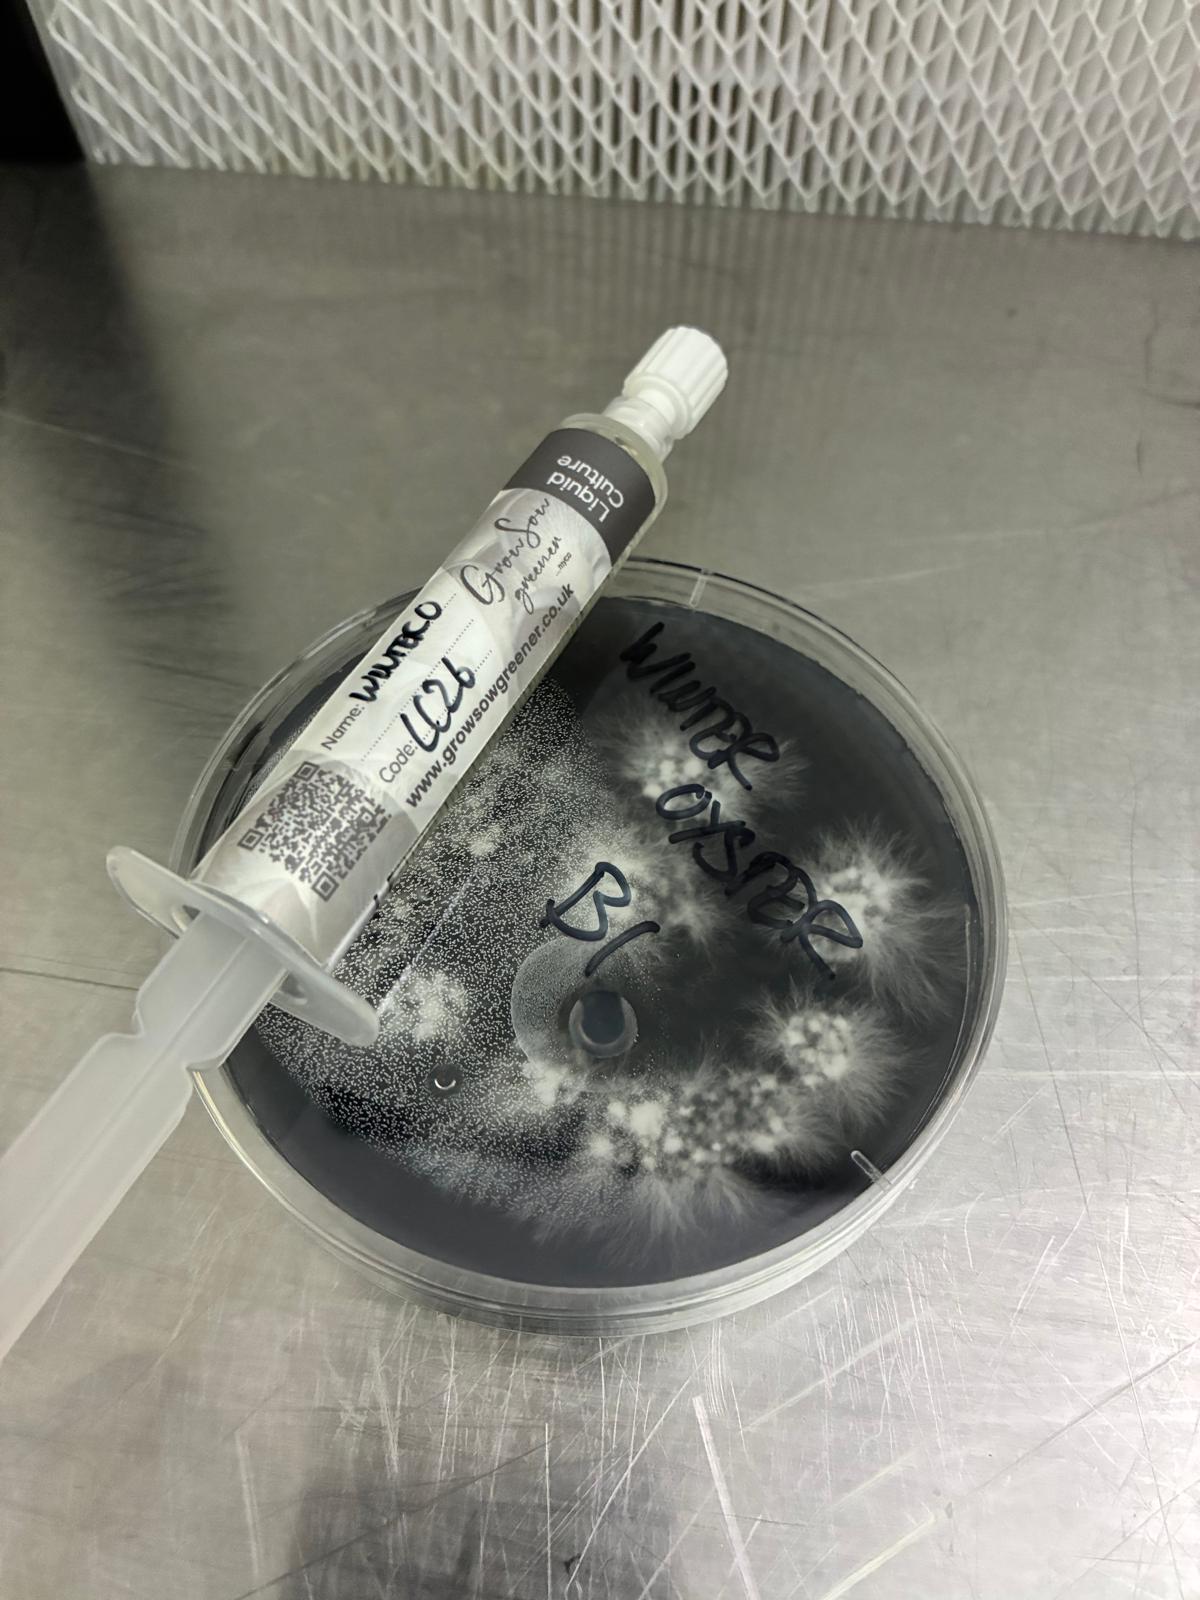

Grow Sow Greener
Winter Oyster Liquid Culture -10ml Syringe
Winter Oyster Liquid Culture -10ml Syringe
Couldn't load pickup availability
Winter Oyster Liquid Culture – 10 ml Sterile Syringe
Species: Pleurotus ostreatus (cold-fruiting strain) | Prepared in the UK
Winter Oyster fruits readily in cool rooms, forming slate-grey clusters with a light, anise-like aroma. It performs when temperatures dip, so it’s useful for unheated spaces and shoulder-season production.
About This Culture
This 10 ml syringe contains actively growing Winter Oyster mycelium in a nutrient broth, produced under sterile workflow. Use it to inoculate grain jars or bags, transfer to agar, or expand to fresh liquid culture under clean conditions.
Included
- 1 × 10 ml Winter Oyster liquid culture syringe
- 1 × sterile needle
- 1 × alcohol wipe
- 1 × natural hemp bag (outer packaging)
Reusable Hemp Bag
The syringe and wipe ship inside an undyed hemp bag. After pasteurising, you can fill the bag with a substrate of your choice (e.g., coffee grounds mixed with sawdust) to create a small, plastic-free gift grow kit for a friend or classroom project.
Use
- Shake to disperse mycelium.
- Clean the injection point (grain bag port or jar lid) with the alcohol wipe.
- Attach sterile needle; flame if working outside filtered air.
- Inject 1–2 ml per grain jar or ~3–5 ml per 1 kg grain bag (adjust to your workflow).
- Incubate grain at 20–24 °C until colonised; shake once ~30–50 % if desired.
- Spawn to supplemented hardwood sawdust (sawdust + bran) at ~10–20 % spawn.
- Fruit blocks at 8–15 °C with high humidity and steady fresh-air exchange. Cooler fruiting deepens cap colour.
Storage
Store refrigerated at 2–6 °C. Best within 2–3 weeks; typically viable up to ~2 months unopened. Do not freeze.
Batch Notes
- Produced in small lots; visually checked on agar before dispatch.
- Light sediment is normal—shake before use.
- Optionally place a drop to agar to confirm purity before large inoculations.
Why Winter Oyster Supports Local Food Systems
- Fruits in cool rooms and unheated spaces, lowering energy demand during winter runs.
- Performs well on supplemented sawdust, making use of local wood by-products.
- Provides reliable cool-season harvests when other fresh produce is scarce, supporting short supply chains.
Lead-time: Made in small batches. We keep limited stock of popular species; if marked back-order please check current lead-time information before ordering.
Shipping
Shipping
Delivery Costs
Our shipping is broken down into two categories and are dispatched the same or next day as standard.
1. Unlimited "Small" (Garden) Seed Packets:
- Including wooden plant markers and sprouting bags.
- £1.99 - Standard Delivery 2 - 4 business days.
- £4.90 Express Delivery 1 - 3 business days
2. Everything Else - Sprouting and Microgreen Seeds, Growing Equipment, Gifts and Grow Kits:
UK Mainland.
- £3.85 - Standard Delivery (2 - 4 business days) on orders between 0 and 2kg.
- £6.50 - Next Day Courier Service on orders 0 - 4.5kg.
- £8.95 - Next Day Courier Service on orders over 4.5kg.
- Contact us for a quote on orders over 26kgs.
Ireland, Northern Ireland, Isle of Man, Guernsey and Jersey.
- £9.45 - Standard Delivery (2 - 4 business days) on orders between 0 and 2kg.
- £23.50 - Standard Delivery on orders 2kg - 26kg.
- Contact us for a quote on orders over 26kg.
The EU, Switzerland and Rest of World.
Get in touch for equipment sales to the EU and the rest of the world for a competitive shipping quote. Unfortunately we cannot yet post seeds outside the UK.
Delivery and Packaging
All products are packaged plastic free as standard. Your garden seeds are sealed for freshness inside white glassine envelopes which are a water/vapour resistant compostable paper product whilst your Microgreen and Sprouting Seeds arrive in resealable zip lock pouches made from GMO free vegetable starch which are further heat sealed to ensure these great products reach you safely!
Returns Policy
Returns Policy
We hope you are loving your purchase however we understand that sometimes things don't go as planned and returns and refunds are necessary. Please refer to the following return and refund policies at growsowgreener.co.uk.
My product is damaged defective or you shipped me the wrong product.
We're sorry about that and understand your frustration! We would love to offer you a refund or a replacement. Please contact us at hi@growsowgreener.co.uk within 30 days of purchase for a full refund or replacement.
I ordered the wrong product or simply changed my mind.
No worries, we will refund you the full amount (minus the shipping charges) provided the items are returned in new condition and in original packaging. Once received we will issue your refund however you will be responsible for return shipping costs for non defective products.
Please post to:
Grow Sow Greener
RETURNS (order number)
5 Longfields
West Alvington
Devon TQ73QG
UK
Guaranteed to grow promise.
Should you have absolutely any problems issues or difficulties getting your seeds to germinate or problems/queries regarding our grow kits or equipment, please get in touch at hi@growsowgreener.co.uk and we will strive to help you out via email, call or video call.
All our seeds and products have been tested here by us however if we still cant help you get growing we will offer a free replacement.
Unfortunately, we cannot accept returns on gift cards.